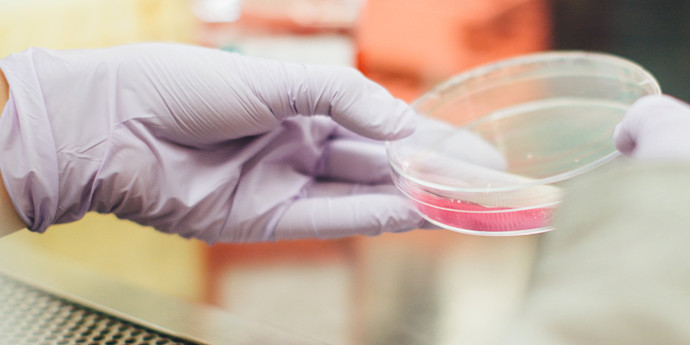
dmla-senior-recherche

DMLA : en bref
La dégénérescence maculaire liée à l’âge (ou DMLA) est une maladie de la rétine causée par une dégénérescence de la macula (partie centrale de la rétine) qui se manifeste généralement chez les personnes de plus de 65 ans. Elle est la première cause de handicap visuel chez les personnes âgées de plus de 50 ans. En France, 1,5 million de personnes ayant plus de 65 ans sont touchées par la maladie. On estime qu’en 2030 ce chiffre grimpera jusqu’à 2,25 millions.
Voici un éclairage sur les symptômes, le diagnostic et le traitement de la DMLA.
- Qu’est ce que la DMLA ?
- Les causes de la maladie
- Les symptômes de la DMLA
- Le traitement de la maladie
- Les conséquences et conseils pour mieux vivre avec la maladie
- Accompagner et prévenir la maladie
- Où en est la recherche sur la DMLA ?
Qu’est-ce que la DMLA ?
Définition de la DMLA
La Dégénérescence maculaire liée à l'âge (DMLA) se définit comme la :
« Destruction progressive de la macula chez les personnes âgées, qui se manifeste par une baisse de la vision centrale ».
Les deux formes de DMLA
La DMLA atrophique ou DMLA sèche
Ce type de DMLA est causé par une atrophie des photorécepteurs (cellules nerveuses sensibles à la lumière) de la macula. C’est la forme de DMLA la plus fréquente qui se caractérise par une évolution lente.
La DMLA exsudative ou DMLA humide
Ce type de DMLA est causé par la création de néo vaisseaux sous la macula qui remplissent la rétine de liquide ou de sang et provoquent donc à terme une atrophie. Cette forme est moins fréquente mais son évolution est bien plus rapide et peut conduire à une perte de la vision centrale en très peu de temps (quelques mois voire semaines).
DMLA : les causes
Les causes de la dégénérescence maculaire restent encore aujourd’hui inconnues. Cependant, certains facteurs semblent accroître les risques, tels que :
- L'âge : la DMLA apparaît après 50 ans et sa fréquence augmente avec le vieillissement ;
- L’hérédité peut parfois jouer dans l’apparition de la maladie ;
- Fumer multiplie par 4 à 6 les risques et accélère sa progression ;
- Les rayons ultraviolets (les yeux de couleur claire sont plus exposés). L’exposition intense à la lumière du jour augmente le risque de développer une DMLA ;
- Des concentrations élevées de cholestéro dans le sang et l'hypertension artérielle ont également été associées à la dégénérescence maculaire. La dégénérescence maculaire humide semble plus fréquente chez les personnes souffrant de maladies cardiovasculaires.
Les symptômes et les diagnostique de la DMLA
Les symptômes
La DMLA est une maladie qui atteint uniquement la partie centrale de la rétine (la macula). Les premiers symptômes ne sont pas toujours évidents à détecter et sont donc souvent négligés : en effet, une baisse de la vision n’est pas forcément à mettre sur le compte d’un vieillissement naturel. Cette maladie dégénérative se manifeste, donc, par les symptômes suivants :
- Une diminution de la sensibilité aux contrastes qui se manifeste par une impression de manque de lumière par exemple au moment de la lecture ;
- Une diminution de l’acuité visuelle qui se traduit par des difficultés à percevoir les détails ;
- Une déformation des lignes droites qui deviennent ondulées ;
- L’apparition d’une tache sombre (noire ou grise) centrale qui gêne autant la vision de loin que celle de près.
Le diagnostic de la DMLA

En cas de symptômes, rapprochez-vous de façon urgente de votre ophtalmologiste en raison du risque d'évolution rapide de certaines formes de DMLA.
Pour dresser un diagnostic, il pourra réaliser :
- Des mesures d’acuité visuelle de près et de loin ;
- Un examen au biomicroscope du segment antérieur des yeux ;
- Un examen du fond d’œil ;
- Une angiographie Cet examen consiste à photographier les vaisseaux de la rétine après injection intraveineuse d’un colorant fluorescent. Il permet de mettre en évidence la DMLA exsudative, ou humide ;
- Une tomographie par cohérence optique (OCT) pour observer plus précisément les différentes couches de la rétine.
Lutter contre la perte d’autonomie, c’est possible !
Gymnastique douce, stimulation cognitive, recettes… Nous vous donnons quelques astuces simples pour stimuler vos proches.
Le traitement de la maladie
La DMLA atrophique ou DMLA sèche
Il n’existe pas de traitement curatif de cette forme de DMLA, cependant plusieurs traitement permettent de ralentir l’avancée de la maladie avec la prescriptions de capsules de compléments alimentaires.
Ces compléments alimentaires ne sont pas remboursés par la Sécurité Sociale cependant un des laboratoires qui fournissent ces capsules (capsules Nutrof Total des laboratoires Théa) les prend à sa charge si les patients sont bénéficiaires de l’APA.
La DMLA exsudative ou DMLA humide
Pour cette forme de DMLA il existe la possibilité de faire des injections intra vitréennes (le vitré étant la partie de l’oeil situé entre la rétine et le cristallin) qui permettent de faire régresser ces néo vaisseaux. Cependant, ce traitement n’est pas permanent et nécessite des contrôles réguliers et souvent d’autres injections.
Les injections intra vitréennes sont remboursées par la Sécurité Sociale.
DMLA : les conséquences et conseils pour mieux vivre avec la maladie
Les conséquences sur le patient

Cette maladie a un impact sur le quotidien des personnes atteintes. En effet, cette forme de malvoyance cause des problèmes dans plusieurs tâches simples du quotidien comme la lecture, l’identification des billets de banque, l’utilisation des appareils numériques. La DMLA entraîne également une perte d’autonomie en ce sens qu’elle cause, dans la plupart des cas, l’arrêt de la conduite, une incapacité à reconnaître certaines personnes dans la rue par exemple. Enfin et surtout, l’altération de la vision augmente le risque de chute et donc le risque de blessures qui en découle.
Accompagner et prévenir la DMLA
Prévention de la maladie
Plusieurs précautions peuvent, en effet, être prises pour mieux préserver sa vue.
Tout d’abord, la nutrition est très importante pour la bonne santé de votre vue. En effet, plusieurs études ont permis de mesurer la responsabilité d’une bonne alimentation dans la prévention de maladie dégénérative comme la DMLA. L’alimentation permettrait donc de ralentir ou de stabiliser l’évolution de la maladie et du vieillissement de la rétine (d’où la prescription de compléments alimentaires dans le cas des DMLA sèche). Trois éléments sont très importants pour agir dans ce sens :
- Acides gras oméga 3, qui se trouvent notamment dans le poisson ; - Lutéine/zéaxanthine et vitamines antioxydantes, que l’on a dans les légumes ; - Le zinc contenu dans des aliments comme les huîtres, le foie, le pain complet ou encore la viande rouge.
Il faut, ensuite, éviter plusieurs facteurs qui peuvent favoriser l’apparition d’une DMLA. Le tabagisme et l’exposition au soleil sans lunettes protectrices sont des facteurs qui multiplient les risques d’apparitions de radicaux libres (molécules qui, produites en excès, s’attaquent aux cellules rétiniennes). De plus, la DMLA a un caractère héréditaire. Il faut donc surveiller l’évolution de votre vue et de l’état de vos rétines si vos parents ont été atteints d’une DMLA.
Enfin, la présence de drusens (dépôts de matériel amorphe sur la rétine) dans les examens du fond d’oeil évolue souvent vers la DMLA. Un contrôle régulier de l’existence de ces drusens est donc très important.
Des conseils pour mieux vivre la maladie au quotidien
Voici quelques conseils pour faciliter le quotidien des personnes atteintes :
- Vérifiez régulièrement que la DMLA ne s’aggrave pas trop rapidement afin que l’autonomie de la personne ne se réduise pas davantage. Un rendez-vous d’urgence chez un ophtalmologiste peut être nécessaire ;
- Suivez les conseils prodigués par l'ophtalmologiste ;
- Aménagez l’intérieur en vous assurant que les tapis soient fixés au sol par exemple. Aussi, évitez les tables basses et les câbles qui traînent. Enfin, pour plus de confort, installez par exemple un téléphone avec de grosses touches ;
- Faites vous accompagner dans les gestes du quotidien. Si la DMLA atteint un stade trop avancé, la question d’une aide à domicile doit se poser pour la personne atteinte. En effet, le ménage, la préparation du repas ou encore les courses sont des tâches qui deviennent difficiles pour les malades.
L’accompagnement par des professionnels permet de soulager le malade dans les actes du quotidien mais aussi de rassurer l’entourage.
Des aides administratives et financières pour être bien accompagné

La DMLA créant une déficience visuel (pour le moment) irréversible, les malades peuvent bénéficier d’aides financières afin de leur faciliter la vie en adaptant leur domicile par exemple. Voici les aides auxquelles les personnes atteintes de DMLA peuvent prétendre :
- L’Allocation Personnalisée d’Autonomie (APA), prestation sociale proposée par le département aux personnes en perte d'autonomie ;
- La Prestation de Compensation du Handicap (PCH), aide financière pour les dépenses liées à la prise en charge du handicap. Cette aide peut donc aider à financer un aménagement du logement ou à financer l’achat de matériel adapté ;
Attention: La PCH et l’APA sont des aides non cumulables. Les personnes atteintes d’une DMLA doivent donc choisir l’aide la mieux adaptée entre les deux.
- Les aides des caisses de retraites, qui proposent des aides financières et matérielles afin de permettre aux personnes en situation de fragilité de continuer à vivre le mieux possible chez eux ;
- Les aides des complémentaires santé, qui sont des aides exceptionnelles qui peuvent être accordées pour aider les patients à payer une prestation ou un traitement non remboursé par la Sécurité Sociale ou pour prendre en charge la cotisation à la complémentaire santé en cas de difficulté de paiement ;
- Les aides de l’Agence Nationale de l’Habitat (ANAH), qui accordent dans certains cas des subventions pour réaliser des travaux (habitat indigne ou dégradé, lutte contre la précarité énergétique, adaptation des logements pour les personnes en perte d’autonomie et redressement de copropriétés en difficulté).
Attention : les travaux ne peuvent pas être commencés avant que la demande de subvention ne soit déposée.
Pour ce qui est de la carte d’invalidité, elle pourra être demandée par les personnes atteintes d’une DMLA mais ne sera accordée qu’en cas de stade avancée de la maladie.
DMLA : où en est la recherche ?
Plusieurs pistes sont explorées par les chercheurs afin de comprendre la maladie d’un point de vue de son origine (découvrir quelles molécules et mécanismes jouent un rôle dans l’apparition et l’évolution de la maladie) et également afin de trouver des traitements efficaces et curatifs (et non seulement des traitements qui empêchent l'évolution de la maladie).
- Pour ce qui est de la DMLA humide, les pistes de recherches explorées sont celles d’une injection intravitréenne qui aurait un effet permanent (cela éviterait donc aux patients de devoir subir une succession d’injections) ;
- Pour la forme sèche, plusieurs équipes dans le monde explorent la piste de la thérapie cellulaire qui vise à implanter des cellules souches. Ces dernières permettraient de constituer un stock de cellules fonctionnelles et d’enrayer le mécanisme de dégénérescence grâce à ces nouvelles cellules. Plusieurs essais ont été lancés dans le monde ;
- Enfin, l’idée de la rétine artificielle fait son chemin. Plusieurs prototypes sont à l’essai (notamment à l’Institut de la Vision à Paris sous la tutelle du Professeur Sahel). Pour le moment les prototypes ne concernent que le traitement de maladies héréditaires de la rétine. Cependant, les prochaines générations d’implants sont en développement et permettront d'élargir le panel de maladies rétiniennes visées par un traitement via cette approche.
En savoir plus sur la DMLA
Pour en savoir plus sur la DMLA, nous vous invitons à consulter ce rapport d’HAS (Haute Autorité de Santé) qui complètera les informations données par cette article. Vous trouverez également beaucoup d’information sur la maladie sur le site de la SFO (Société Française d’Ophtalmologie). Pour les personnes atteintes de DMLA, voici également le site internet de deux associations qui ont pour but de soutenir, écouter informer les patients :
-
Association DMLA ; -
Retina France.
Préserver la vue des seniors ● Lexique complet de la dépendance ● Maintien à domicile des personnes âgées